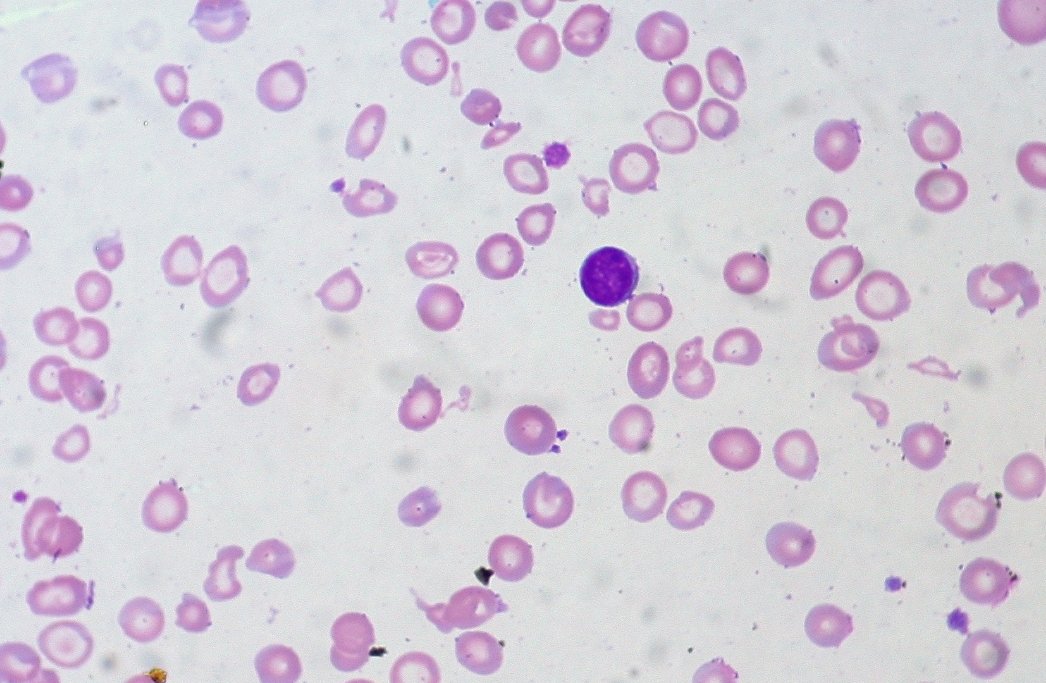
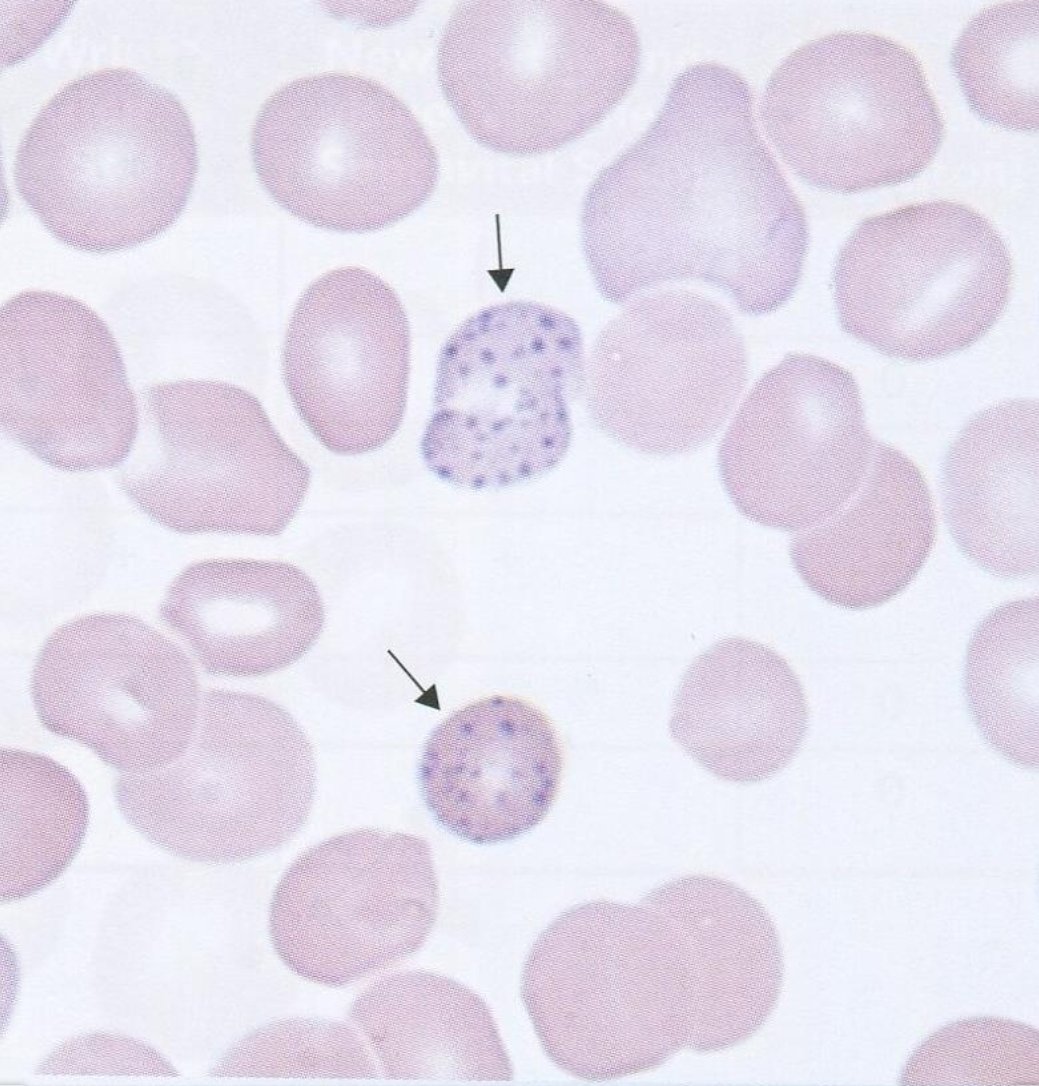
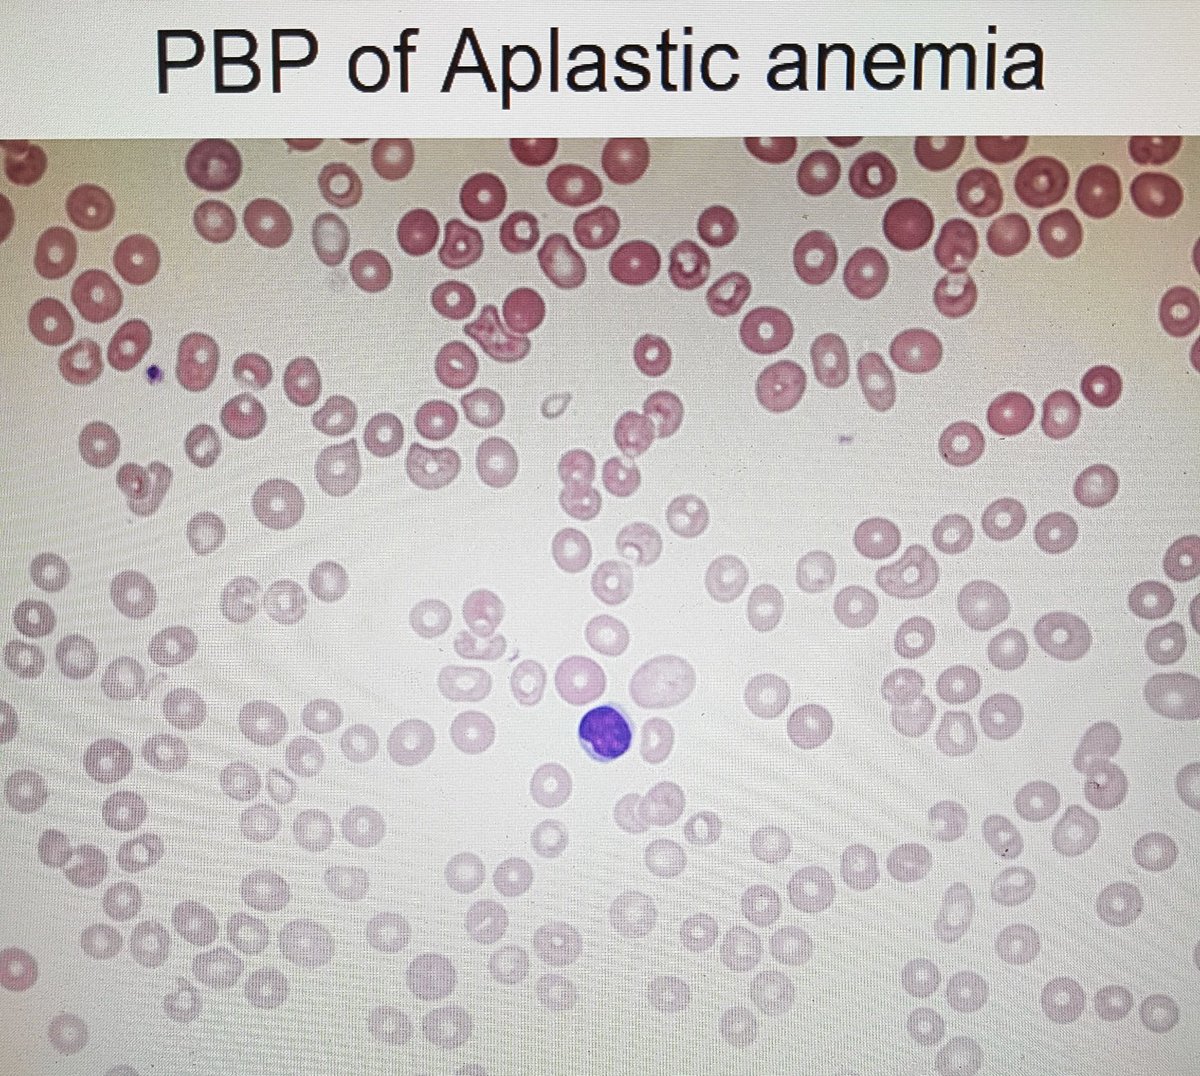
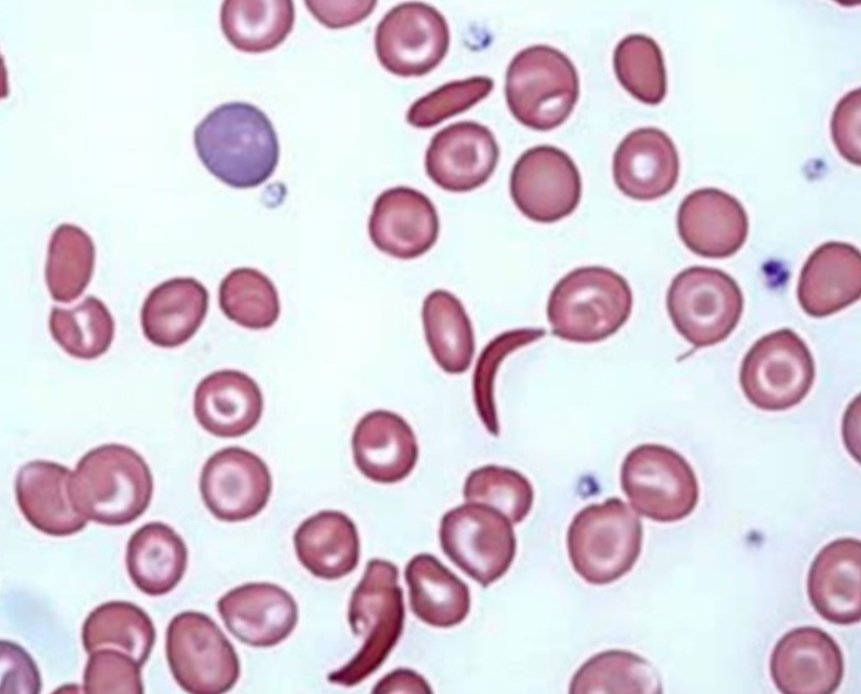

فقر الدم ( Anemia ):
نقص مستوى الهيموقلوبين عن المستوى الطبيعي، بالتالي قد يشكوا المرضى من علامات وأعراض مثل ( الإرهاق، الصداع، عدم التركيز )
قد يؤدي الى نقص مستوى الأوكسجين في الأنسجة، ضعف في الجهاز التنفسي، إضطراب القلب والأوعية الدموية.
نقص مستوى الهيموقلوبين عن المستوى الطبيعي، بالتالي قد يشكوا المرضى من علامات وأعراض مثل ( الإرهاق، الصداع، عدم التركيز )
قد يؤدي الى نقص مستوى الأوكسجين في الأنسجة، ضعف في الجهاز التنفسي، إضطراب القلب والأوعية الدموية.
فقر الدم بسبب نقص الحديد ( IDA ):
الحديد عنصر مهم في تكوين الهيموقلوبين، فنقصانه يؤدي الى نقصان إنتاج الهيموقلوبين بالتالي تنتج خلايا حمراء بحجم صغير بصِبغة ناقصه (hypochromic)، من أعراضه التعب والإعياء، أضافر هشه او على شكل ملعقه، التهاب اللسان و الرغبه في تناول مواد غير غذائية.
الحديد عنصر مهم في تكوين الهيموقلوبين، فنقصانه يؤدي الى نقصان إنتاج الهيموقلوبين بالتالي تنتج خلايا حمراء بحجم صغير بصِبغة ناقصه (hypochromic)، من أعراضه التعب والإعياء، أضافر هشه او على شكل ملعقه، التهاب اللسان و الرغبه في تناول مواد غير غذائية.
اختبارات الحديد ( Iron profile ):
• serum iron: مستوى الحديد في الدم
• serum ferritin:
بروتين يستخدم لتخزين الحديد، يعتبر الاكثر تخصصا ( في حال عدم وجود عدوا او التهاب ).
•Transferrine & total-iron binding capacity (TIBC):
-transferrin; بروتين ناقل للحديد في الدم.
يتبع
• serum iron: مستوى الحديد في الدم
• serum ferritin:
بروتين يستخدم لتخزين الحديد، يعتبر الاكثر تخصصا ( في حال عدم وجود عدوا او التهاب ).
•Transferrine & total-iron binding capacity (TIBC):
-transferrin; بروتين ناقل للحديد في الدم.
يتبع
- Alpha-Thalassemia:
يعتمد على الطفرات المتواجده في الجين (على كروموسوم 16)؛
• طفرة واحدة يعتبر حاملا فقط(لايعتبر مريض).
• طفرتان، يعتبر فقر دم بسيط تسمى ب الصغرى (Minor) باعراض طفيفه .
• ثلاث طفرات، تسمى ب (Hemoglobin H disease) يستدعي نقل للدم طوال الحياة.
يتبع
يعتمد على الطفرات المتواجده في الجين (على كروموسوم 16)؛
• طفرة واحدة يعتبر حاملا فقط(لايعتبر مريض).
• طفرتان، يعتبر فقر دم بسيط تسمى ب الصغرى (Minor) باعراض طفيفه .
• ثلاث طفرات، تسمى ب (Hemoglobin H disease) يستدعي نقل للدم طوال الحياة.
يتبع
• أربع طفرات، تسمى بالكبرى (Major)
يموت الجنين قبل او بعد ولادته بفترة قليله حيث يصاب بفقر دم حاد جدا (hydrops fetalis)(youtu.be)
- Beta-Thalassemia:
•طفرة جينية واحدة تسمى بالصغرى (Minor) بأعراض طفيفة.
• طفرتان جينيتان تسمى بالكبرى (Major) تصيب هيموقلوبين A.
يموت الجنين قبل او بعد ولادته بفترة قليله حيث يصاب بفقر دم حاد جدا (hydrops fetalis)(youtu.be)
- Beta-Thalassemia:
•طفرة جينية واحدة تسمى بالصغرى (Minor) بأعراض طفيفة.
• طفرتان جينيتان تسمى بالكبرى (Major) تصيب هيموقلوبين A.
Megaloblastic anemia:
هي حالة ينتج فيها نخاع العظام خلايا دم حمراء كبيرة بشكل غير طبيعية وغير ناضجة، قد تحدث للعدة اسباب منها؛
هي حالة ينتج فيها نخاع العظام خلايا دم حمراء كبيرة بشكل غير طبيعية وغير ناضجة، قد تحدث للعدة اسباب منها؛
فقر دم الفول (Favism):
ناتج عن نقصان إنزيم
Glucose-6- Phosphate-dehydrogenase
إنزيم يساعد الخلايا الحمراء على العمل ويحميها من الضرر، تظهر أعراض مثل الخمول، ارتفاع نبضات القلب، صعوبه في التنفس، اليرقان وتضخم الطحال ( تضهر بعنف بعد تناول الفول او استنشاق حبوب لقاح زهرة الفول).
ناتج عن نقصان إنزيم
Glucose-6- Phosphate-dehydrogenase
إنزيم يساعد الخلايا الحمراء على العمل ويحميها من الضرر، تظهر أعراض مثل الخمول، ارتفاع نبضات القلب، صعوبه في التنفس، اليرقان وتضخم الطحال ( تضهر بعنف بعد تناول الفول او استنشاق حبوب لقاح زهرة الفول).
جاري تحميل الاقتراحات...